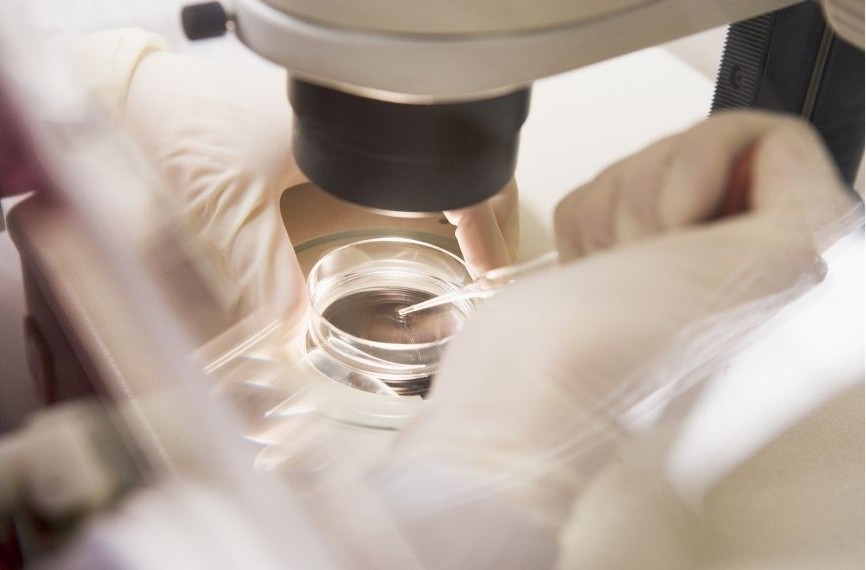

妊娠お悩み相談
(妊娠よろず相談外来)
妊娠をめざすうえでのご心配事を解消します。
近年は晩婚化・晩産化の影響もあり、
- 妊娠したくてもなかなかできない(不妊症)
- 妊娠しても流産や死産となってしまった(不育症)
- 過去の妊娠で異常があり次の妊娠が心配
- 子宮や卵巣に病気があってこのまま妊娠してよいか分からない
- 持病があって妊娠に問題が生じないか不安がある
など、妊娠に対してさまざまなお悩みを抱えた女性が増えています。 しかし、そうしたお悩みの相談先は多くないのが現状です。
不育症とは
妊娠はするものの流産や死産、新生児死亡(生後1週間未満の死亡)を繰り返し元気な赤ちゃんを産むことができない状態をいいます。
また過去の妊娠で早産、妊娠高血圧症候群、胎児発育不全(赤ちゃんが妊娠週数に比べて小さい)などを経験された方も相談していただけます。

難治性不妊症とは
不妊症とは、妊娠を希望し避妊せずに通常の性生活を続けた場合に1年以上たっても妊娠に至らない状態をいいます。
難治性不妊症とは、一般的な不妊治療を行ってもなかなか妊娠に至らない方をさします。そうした方を対象に原因や治療法の相談に乗ります。
そこで、当院の成田バースセンターでは、妊娠前のあらゆる悩みに対して医学的な観点から適切なアドバイスを行い、必要であれば治療およびその後の妊娠計画を設定する専門外来として、「妊娠よろず相談外来」を毎週金曜日午後に開設しています。
受診をご希望の方は当院の予約センター(0476-35-5576)までご連絡ください。
★1人30分程度の時間をかけて、しっかり相談することができます。
★1回の相談で自由診療の場合は5,000円〜10,000円程度の費用をいただいています。保険診療となる場合は一般的な保険点数による費用負担となります。
